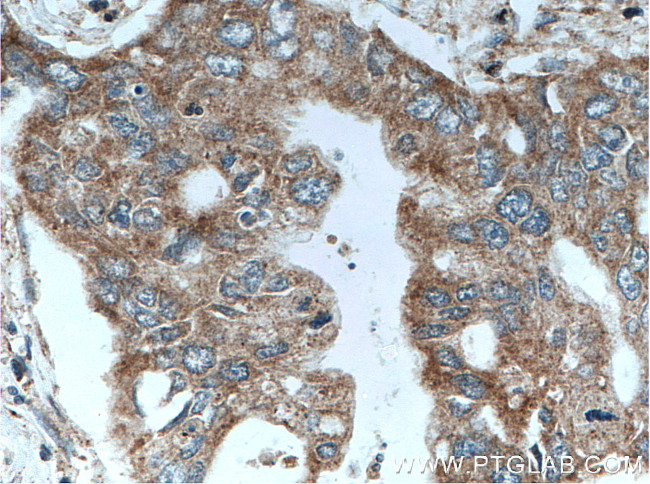
CRH/CRF Antibody in Immunohistochemistry (Paraffin) (IHC (P))

Search
Proteintech
CRH/CRF Polyclonal Antibody
{{$productOrderCtrl.translations['antibody.pdp.commerceCard.promotion.promotions']}}
{{$productOrderCtrl.translations['antibody.pdp.commerceCard.promotion.viewpromo']}}
{{$productOrderCtrl.translations['antibody.pdp.commerceCard.promotion.promocode']}}: {{promo.promoCode}} {{promo.promoTitle}} {{promo.promoDescription}}. {{$productOrderCtrl.translations['antibody.pdp.commerceCard.promotion.learnmore']}}
产品信息
10944-1-AP
宿主/亚型
分类
类型
抗原
偶联物
形式
浓度
规格
保存条件
运输条件
产品详细信息
Aliquoting is unnecessary for -20°C storage.
靶标信息
Corticotropin Releasing Factor (CRF), a 41 amino acids neuropeptide, belongs to a family of structurally related peptides including urocortin, sauvagine and urotensin I. CRF is critical in the regulation of the pituitary-adrenal gland axis, and in endocrine, autonomic and behavioral responses to stress. CRF is widely distributed in the brain and peripheral nervous system with the highest levels in the hypothalamic paraventricular nucleus.
仅用于科研。不用于诊断过程。未经明确授权不得转售。